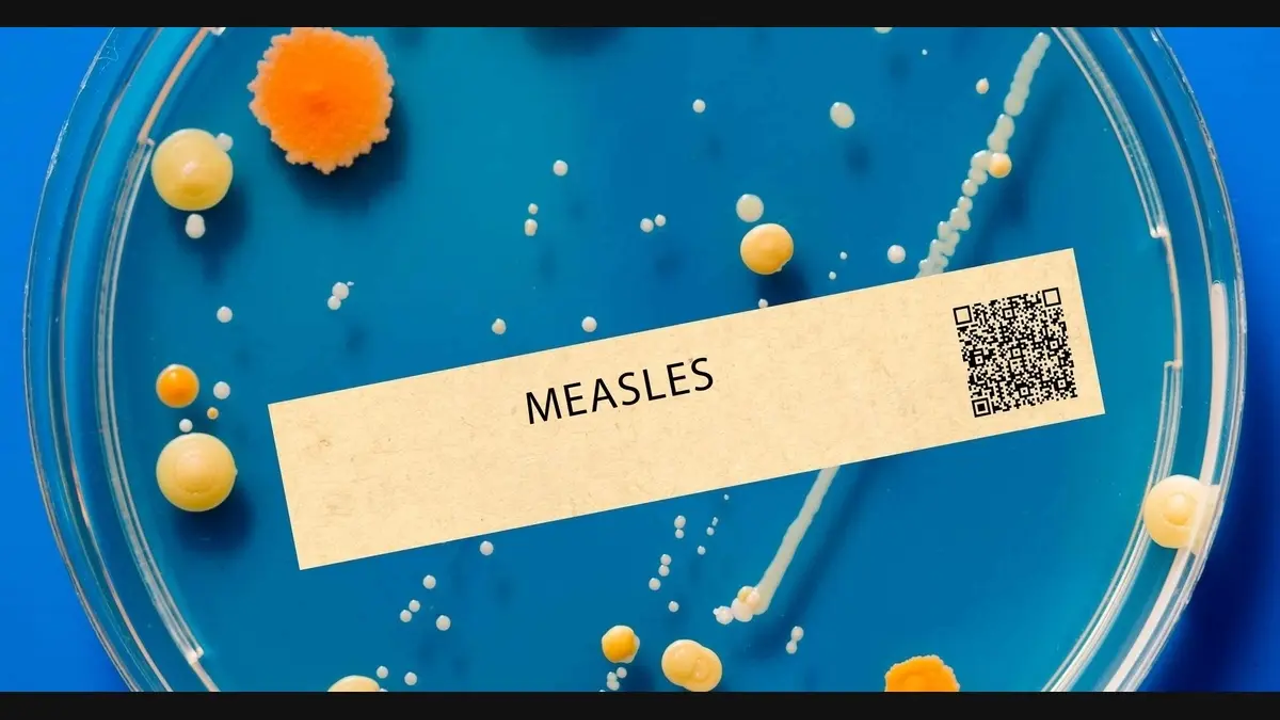
Airfind news item

MD Confirms 2 New Measles Cases
By Gaby Arancibia
Published on April 24, 2026.
The Maryland Department of Health has confirmed two new measles cases, linked to Marylanders who traveled to an area in the US with active measles transmission. The source of exposure is not yet known, but officials are working to identify individuals who may have been exposed. The cases were not specified where the individuals had traveled. The measles virus can remain in the air for two hours and spread through direct contact after touching a contaminated area. Anyone exposed to these locations during these times should monitor themselves for any early symptoms of measles for 21 days after the potential exposure. Those who have received two measles-containing vaccines or were born before 1957 are generally considered protected. The Maryland Health Department recommends fully vaccinated against measles, with the measles vaccine being recommended at 12–15 months of age for the first dose and the second dose at 4–6 years old.


